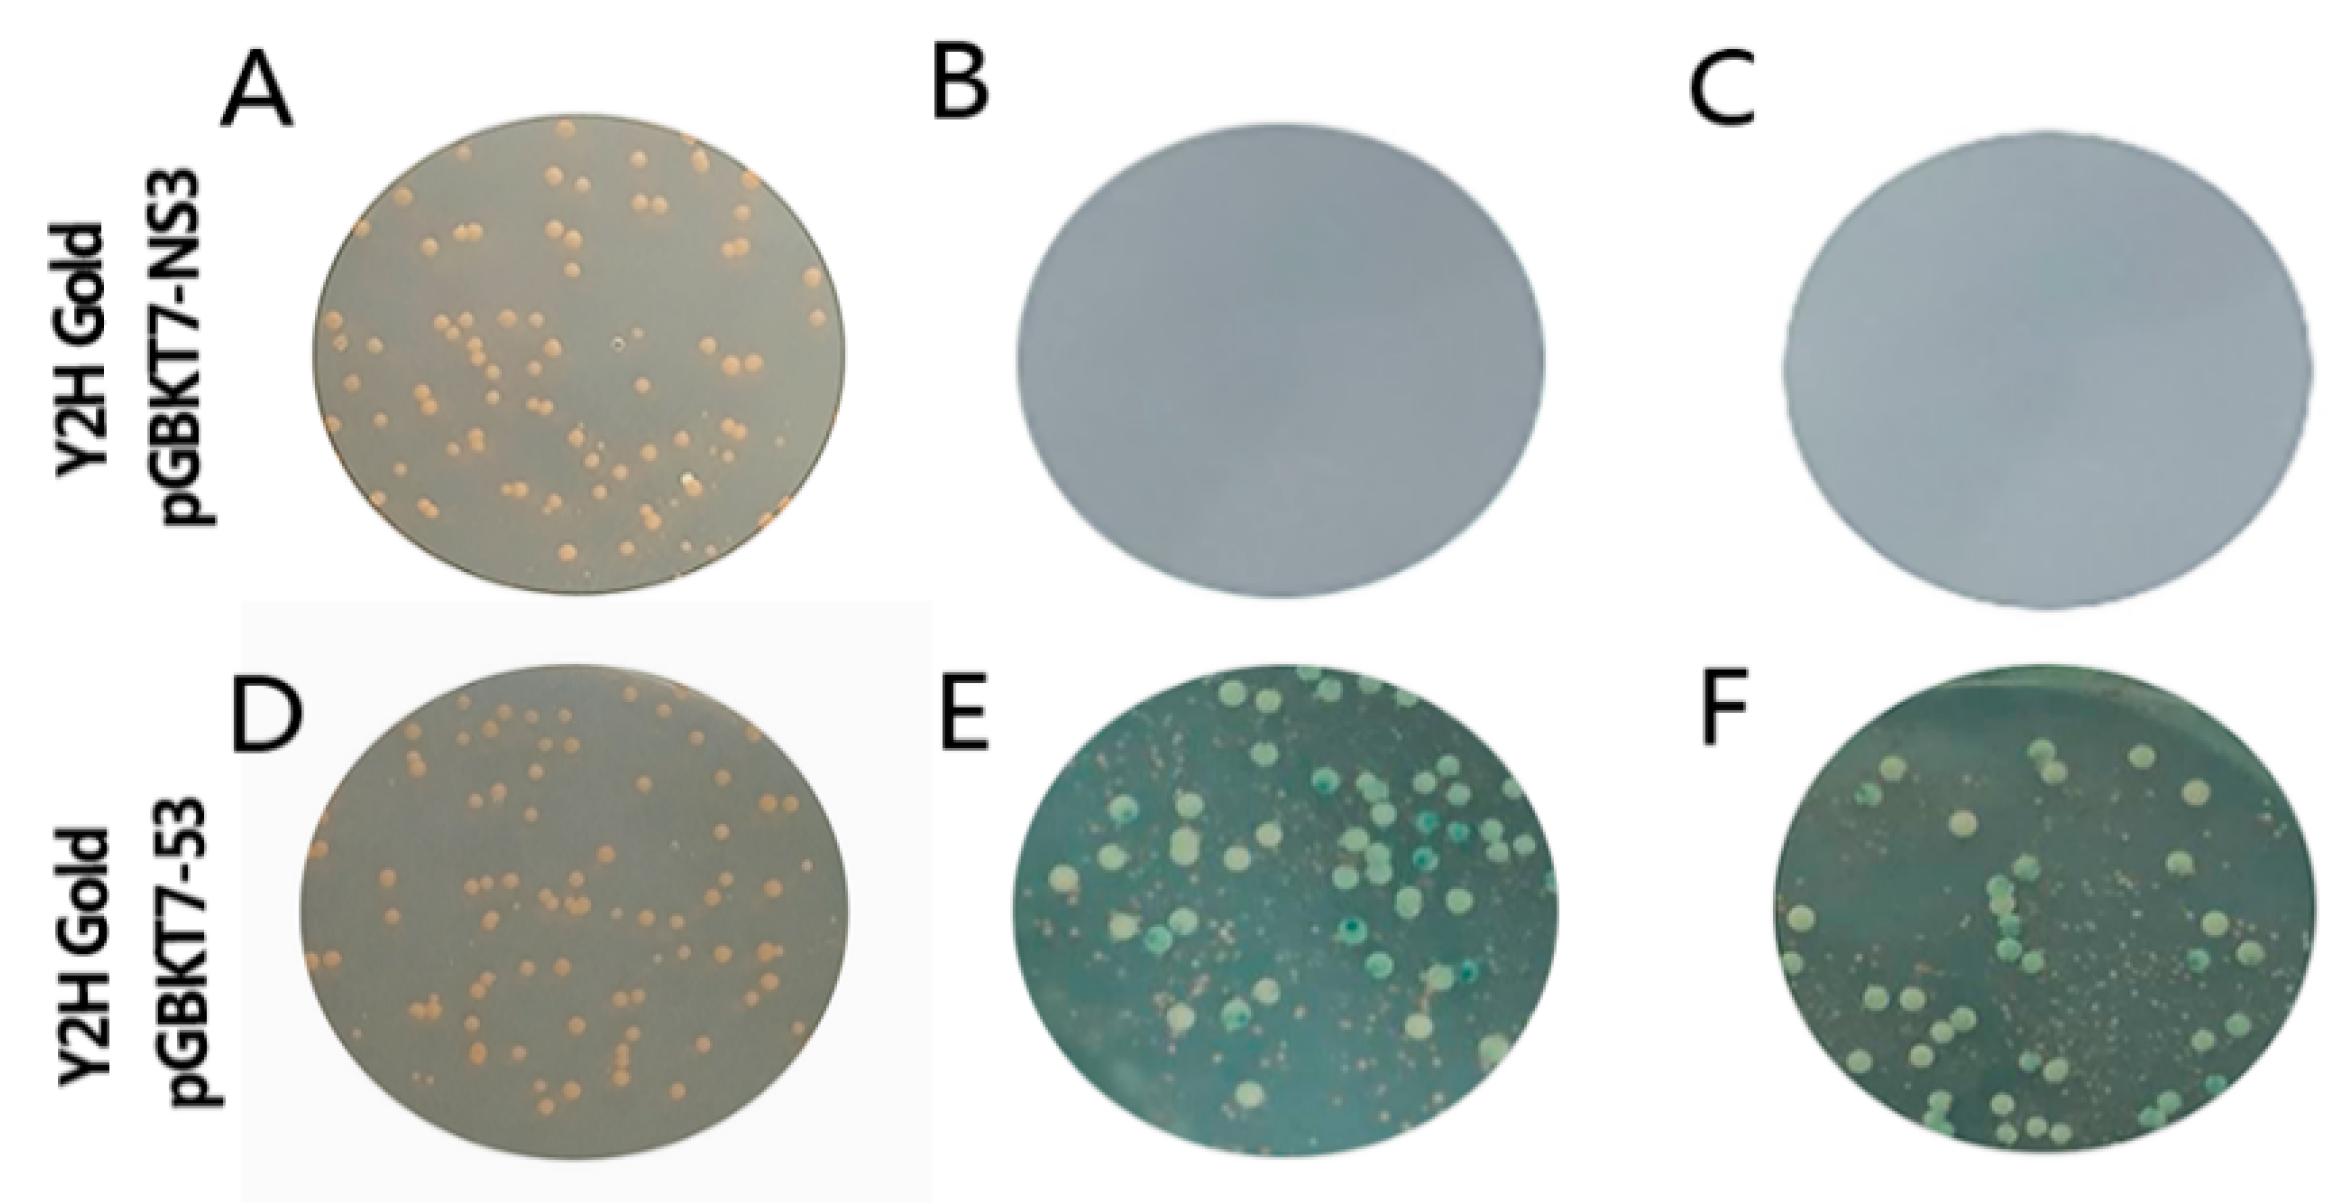
Viruses 11 00740 g002

Screening of Duck Tembusu Virus NS3 Interacting Host Proteins and Identification of Its Specific Interplay Domains
Abstract
1. Introduction
2. Materials and Methods
2.1. Y2H Assays
2.1.1. Bait Yeast Strain Preparation
2.1.2. Autoactivation and Toxicity Test
2.1.3. Mating and Screening
2.2. Regressive Verification
2.3. Laser Scanning Confocal Microscopy Observation
2.4. Intracellular Reactive Oxygen Species (ROS) Detection
2.5. Glutathione S-transferase (GST) Pull-Down Assay
2.6. Real-time Polymerase Chain Reaction (PCR) and Phosphorylation Level of p38
3. Results
3.1. Construction of the Recombinant Plasmid
3.2. Testing Autoactivation and Toxicity
3.3. Screening of Mate & Plate Library
3.4. RNA-seq Analysis of Duck Tembusu Virus (DTMUV)-infected Cells
3.5. Intracellular Reactive Oxygen Species (ROS) Level Detection
3.6. Regressive Verification
3.7. Co-Localization of PRDX1 and HELICc
3.8. Glutathione S-transferase (GST) Pull-Down Assay
3.9. Real-Time Polymerase Chain Reaction (PCR) and p38 Phosphorylation Analysis
4. Discussion
Author Contributions
Funding
Conflicts of Interest
References
- Cao, Z.; Zhang, C.; Liu, Y.; Ye, W.; Han, J.; Ma, G.; Zhang, D.; Xu, F.; Gao, X.; Tang, Y.; et al. Tembusu virus in ducks, China. Emerg. Infect. Dis. 2011, 17, 1873–1875. [Google Scholar] [CrossRef] [PubMed]
- Su, J.; Li, S.; Hu, X.; Yu, X.; Wang, Y.; Liu, P.; Lu, X.; Zhang, G.; Hu, X.; Liu, D.; et al. Duck egg-drop syndrome caused by BYD virus, a new Tembusu-related flavivirus. PLoS ONE. 2011, 6, e18106. [Google Scholar] [CrossRef] [PubMed]
- Halstead, S.M. Dengue and dengue hemorrhagic fever. In Handbook of Zoonoses, Section B: Viral Zoonoses, 2nd ed.; CRC Press: Boca Raton, FL, USA, 2017; pp. 321–329. [Google Scholar]
- Turtle, L.; Griffiths, M.J.; Solomon, T. Encephalitis caused by flaviviruses. QJM. 2012, 105, 219–223. [Google Scholar] [CrossRef] [PubMed]
- Gould, E.; Solomon, T. Pathogenic flaviviruses. Lancet. 2008, 371, 500–509. [Google Scholar] [CrossRef]
- Liu, P.P.; Lu, H.; Li, S.; Wu, Y.; Gao, G.F.; Su, J.L. Duck egg drop syndrome virus: An emerging Tembusu-related flavivirus in China. Sci. China Life Sci. 2013, 56, 701–710. [Google Scholar] [CrossRef] [PubMed]
- Chambers, T. Flavivirus Genome Organization, Expression, And Replication. Annu. Rev. Microbiol. 2002, 44, 649–688. [Google Scholar] [CrossRef] [PubMed]
- Suthar, M.S.; Aguirre, S.; Fernandez-Sesma, A. Innate Immune Sensing of Flaviviruses. PLoS Pathog. 2013, 9, e1003541. [Google Scholar] [CrossRef] [PubMed]
- Brand, C.; Bisaillon, M.; Geiss, B.J. Organization of the Flavivirus RNA replicase complex. Wiley Interdiscip. Rev. RNA. 2017, 8, 1437. [Google Scholar] [CrossRef] [PubMed]
- Diamond, M.S. Evasion of innate and adaptive immunity by flaviviruses. Immunol. Cell Biol. 2003, 81, 196–206. [Google Scholar] [CrossRef] [PubMed]
- Chua, J.J.E.; Ng, M.M.L.; Chow, V.T.K. The non-structural 3 (NS3) protein of dengue virus type 2 interacts with human nuclear receptor binding protein and is associated with alterations in membrane structure. Virus Res. 2004, 102, 151–163. [Google Scholar] [CrossRef] [PubMed]
- Luo, D.; Xu, T.; Hunke, C.; Gruber, G.; Vasudevan, S.; Lescar, J. Crystal structure of the NS3 protease-helicase from dengue virus. J. Virol. 2008, 82, 173–183. [Google Scholar] [CrossRef] [PubMed]
- Luo, D.; Vasudevan, S.G.; Lescar, J. The flavivirus NS2B-NS3 protease-helicase as a target for antiviral drug development. Antivir. Res. 2015, 118, 148–158. [Google Scholar] [CrossRef] [PubMed]
- Leung, D.; Schroder, K.; White, H.; Fang, N.X.; Stoermer, M.J.; Abbenante, G.; Martin, J.L.; Young, P.R.; Fairlie, D.P. Activity of Recombinant Dengue 2 Virus NS3 Protease in the Presence of a Truncated NS2B Co-factor, Small Peptide Substrates, and Inhibitors. J. Biol. Chem. 2001, 276, 45762–45771. [Google Scholar] [CrossRef] [PubMed]
- Wu, J.; Bera, A.K.; Kuhn, R.J.; Smith, J.L. Structure of the Flavivirus Helicase: Implications for Catalytic Activity, Protein Interactions, and Proteolytic Processing. J. Virol. 2005, 79, 10268–10277. [Google Scholar] [CrossRef] [PubMed]
- Yon, C.; Teramoto, T.; Mueller, N.; Phelan, J.; Ganesh, V.K.; Murthy, K.H.M.; Padmanabhan, R. Modulation of the nucleoside triphosphatase/RNA helicase and 5′-RNA triphosphatase activities of dengue virus type 2 nonstructural protein 3 (NS3) by interaction with NS5, the RNA-dependent RNA polymerase. J. Biol. Chem. 2005, 280, 27412–27419. [Google Scholar] [CrossRef] [PubMed]
- Ghosh, A.; Lima, C.D. Enzymology of RNA cap synthesis. Wiley Interdiscip. Rev. RNA. 2010, 1, 152–172. [Google Scholar] [CrossRef] [PubMed]
- Cui, T.; Sugrue, R.J.; Xu, Q.; Lee, A.K.W.; Chan, Y.C.; Fu, J. Recombinant dengue virus type 1 NS3 protein exhibits specific viral RNA binding and NTPase activity regulated by the NS5 protein. Virology. 1998, 246, 409–417. [Google Scholar] [CrossRef] [PubMed]
- Luo, D.; Xu, T.; Watson, R.P.; Scherer-Becker, D.; Sampath, A.; Jahnke, W.; Yeong, S.S.; Wang, C.H.; Lim, S.P.; Strongin, A.; et al. Insights into RNA unwinding and ATP hydrolysis by the flavivirus NS3 protein. EMBO J. 2008, 27, 3209–3219. [Google Scholar] [CrossRef]
- Gebhard, L.G.; Kaufman, S.B.; Gamarnik, A.V. Novel ATP-independent RNA annealing activity of the dengue virus NS3 helicase. PLoS ONE. 2012, 7, e36244. [Google Scholar] [CrossRef]
- Ivanyi-Nagy, R.; Darlix, J.L. Reprint of: Core protein-mediated 5’-3’ annealing of the West Nile virus genomic RNA in vitro. Virus Res. 2012, 169, 448–457. [Google Scholar] [CrossRef]
- Mastrangelo, E.; Bolognesi, M.; Milani, M. Flaviviral helicase: Insights into the mechanism of action of a motor protein. Biochem. Biophys. Res. Commun. 2012, 417, 84–87. [Google Scholar] [CrossRef]
- Shiryaev, S.A.; Chernov, A.V.; Aleshin, A.E.; Shiryaeva, T.N.; Strongin, A.Y. NS4A regulates the ATPase activity of the NS3 helicase: A novel cofactor role of the non-structural protein NS4A from West Nile virus. J. Gen. Virol. 2009, 90, 2081–2085. [Google Scholar] [CrossRef]
- Wölk, B.; Sansonno, D.; Kräusslich, H.G.; Dammacco, F.; Rice, C.M.; Blum, H.E.; Moradpour, D. Subcellular localization, stability, and trans-cleavage competence of the hepatitis C virus NS3-NS4A complex expressed in tetracycline-regulated cell lines. J. Virol. 2000, 74, 2293–2304. [Google Scholar] [CrossRef]
- Papageorgiou, L.; Loukatou, S.; Sofia, K.; Maroulis, D.; Vlachakis, D. An updated evolutionary study of Flaviviridae NS3 helicase and NS5 RNA-dependent RNA polymerase reveals novel invariable motifs as potential pharmacological targets. Mol. Biosyst. 2016, 12, 2080–2093. [Google Scholar] [CrossRef]
- Causier, B.; Davies, B. Analysing protein-protein interactions with the yeast two-hybrid system. Plant Mol. Biol. 2002, 50, 855–870. [Google Scholar] [CrossRef]
- Coates, P.J.; Hall, P.A. The yeast two-hybrid system for identifying protein-protein interactions. J. Pathol. 2003, 199, 4–7. [Google Scholar] [CrossRef]
- Hamzeh-Mivehroud, M.; Alizadeh, A.A.; Morris, M.B.; Bret Church, W.; Dastmalchi, S. Phage display as a technology delivering on the promise of peptide drug discovery. Drug Discov. Today. 2013, 18, 1144–1157. [Google Scholar] [CrossRef]
- Takahashi, Y. Co-immunoprecipitation from transfected cells. In Protein-Protein Interactions: Methods and Applications, 2nd ed.; Humana Press: New York, NY, USA, 2015; pp. 381–389. [Google Scholar]
- Newton, A.C.; Schechtman, D.; Mochly-Rosen, D.; Ron, D. Glutathione S-Transferase Pull-Down Assay. In Protein Kinase C Protocols.; Humana Press: New York, NY, USA, 2003; pp. 345–350. [Google Scholar]
- Ozawa, R.; Yoshida, M.; Hattori, M.; Sakaki, Y.; Chiba, T.; Ito, T. A comprehensive two-hybrid analysis to explore the yeast protein interactome. Proc. Natl. Acad. Sci. USA 2002, 98, 4569–4574. [Google Scholar]
- Wagemans, J.; Lavigne, R. Identification of protein-protein interactions by standard Gal4p-based yeast two-hybrid screening. In Protein-Protein Interactions: Methods and Applications, 2nd ed.; Humana Press: New York, NY, USA, 2015; pp. 409–431. [Google Scholar]
- Walhout, A.J.M.; Vidal, M. A genetic strategy to eliminate self-activator baits prior to high-throughput yeast two-hybrid screens. Genome Res. 1999, 9, 1128–1134. [Google Scholar] [CrossRef]
- Brückner, A.; Polge, C.; Lentze, N.; Auerbach, D.; Schlattner, U. Yeast two-hybrid, a powerful tool for systems biology. Int. J. Mol. Sci. 2009, 10, 2763–2788. [Google Scholar] [CrossRef]
- Nakayama, M.; Kikuno, R.; Ohara, O. Protein-protein interactions between large proteins: Two-hybrid screening using a functionally classified library composed of long cDNAs. Genome Res. 2002, 12, 1773–1784. [Google Scholar] [CrossRef]
- Gebicki, J.M. Oxidative stress, free radicals and protein peroxides. Arch. Biochem. Biophys. 2016, 595, 33–39. [Google Scholar] [CrossRef]
- Bhat, A.H.; Dar, K.B.; Anees, S.; Zargar, M.A.; Masood, A.; Sofi, M.A.; Ganie, S.A. Oxidative stress, mitochondrial dysfunction and neurodegenerative diseases; a mechanistic insight. Biomed. Pharmacother. 2015, 74, 101–110. [Google Scholar] [CrossRef]
- Cook, C.; Petrucelli, L. Oxidative stress. In Parkinson’s Disease, 2nd ed.; CRC Press: Boca Raton, FL, USA, 2012; pp. 455–459. [Google Scholar]
- Valko, M.; Leibfritz, D.; Moncol, J.; Cronin, M.T.D.; Mazur, M.; Telser, J. Free radicals and antioxidants in normal physiological functions and human disease. Int. J. Biochem. Cell Biol. 2007, 39, 44–84. [Google Scholar] [CrossRef]
- Prasad, S.; Gupta, S.C.; Tyagi, A.K. Reactive oxygen species (ROS) and cancer: Role of antioxidative nutraceuticals. Cancer Lett. 2017, 387, 95–105. [Google Scholar] [CrossRef]
- Rajendran, P.; Nandakumar, N.; Rengarajan, T.; Palaniswami, R.; Gnanadhas, E.N.; Lakshminarasaiah, U.; Gopas, J.; Nishigaki, I. Antioxidants and human diseases. Clin. Chim. Acta. 2014, 436, 332–347. [Google Scholar] [CrossRef]
- Sevilla, F.; Camejo, D.; Ortiz-Espín, A.; Calderón, A.; Lázaro, J.J.; Jiménez, A. The thioredoxin/peroxiredoxin/sulfiredoxin system: Current overview on its redox function in plants and regulation by reactive oxygen and nitrogen species. J. Exp. Bot. 2015, 66, 2945–2955. [Google Scholar] [CrossRef]
- Ray, P.D.; Huang, B.W.; Tsuji, Y. Reactive oxygen species (ROS) homeostasis and redox regulation in cellular signaling. Cell. Signal. 2012, 24, 981–990. [Google Scholar] [CrossRef]
- Neumann, C.A.; Krause, D.S.; Carman, C.V.; Das, S.; Dubey, D.P.; Abraham, J.L.; Bronson, R.T.; Fujiwara, Y.; Orkin, S.H.; Van Etten, R.A. Essential role for the peroxiredoxin Prdx1 in erythrocyte antioxidant defence and tumour suppression. Nature. 2003, 424, 561–565. [Google Scholar] [CrossRef]
- Ding, C.; Fan, X.; Wu, G. Peroxiredoxin 1—An antioxidant enzyme in cancer. J. Cell. Mol. Med. 2017, 21, 193–202. [Google Scholar] [CrossRef]
- Pannala, V.R.; Dash, R.K. Mechanistic characterization of the thioredoxin system in the removal of hydrogen peroxide. Free Radic. Biol. Med. 2015, 78, 42–55. [Google Scholar] [CrossRef]
- Rhee, S.G.; Kil, I.S. Multiple Functions and Regulation of Mammalian Peroxiredoxins. Annu. Rev. Biochem. 2017, 86, 749–775. [Google Scholar] [CrossRef]
- Rhee, S.G.; Woo, H.A.; Kang, D. The Role of Peroxiredoxins in the Transduction of H2O2 Signals. Antioxid. Redox Signal. 2017, 28, 537–557. [Google Scholar] [CrossRef]
- Park, M.H.; Jo, M.; Kim, Y.R.; Lee, C.K.; Hong, J.T. Roles of peroxiredoxins in cancer, neurodegenerative diseases and inflammatory diseases. Pharmacol. Ther. 2016, 163, 1–23. [Google Scholar] [CrossRef]
- Huang, Q.; Zhou, H.J.; Zhang, H.; Huang, Y.; Hinojosa-Kirschenbaum, F.; Fan, P.; Yao, L.; Belardinelli, L.; Tellides, G.; Giordano, F.J.; et al. Thioredoxin-2 inhibits mitochondrial reactive oxygen species generation and apoptosis stress kinase-1 activity to maintain cardiac function. Circulation. 2015, 131, 1082–1097. [Google Scholar] [CrossRef]
- Wada, T.; Penninger, J.M. Mitogen-activated protein kinases in apoptosis regulation. Oncogene. 2004, 23, 2838–2849. [Google Scholar] [CrossRef]
- Tobiume, K.; Matsuzawa, A.; Takahashi, T.; Nishitoh, H.; Morita, K.I.; Takeda, K.; Minowa, O.; Miyazono, K.; Noda, T.; Ichijo, H. ASK1 is required for sustained activations of JNK/p38 MAP kinases and apoptosis. EMBO Rep. 2001, 2, 222–228. [Google Scholar] [CrossRef]
- Nagai, H.; Noguchi, T.; Takeda, K.; Ichijo, H. Pathophysiological Roles of ASK1-MAPKinase Signaling Pathways. BMB Rep. 2011, 40, 1–6. [Google Scholar] [CrossRef]
- Saitoh, M.; Nishitoh, H.; Fujii, M.; Takeda, K.; Tobiume, K.; Sawada, Y.; Kawabata, M.; Miyazono, K.; Ichijo, H. Mammalian thioredoxin is a direct inhibitor of apoptosis signal-regulating kinase (ASK) 1. EMBO J. 1998, 17, 2596–2606. [Google Scholar] [CrossRef]
- Hayakawa, R.; Hayakawa, T.; Takeda, K.; Ichijo, H. Therapeutic targets in the ASK1-dependent stress signaling pathways. Proc. Jpn. Acad. Ser. B. 2012, 88, 434–453. [Google Scholar] [CrossRef]
- Nordberg, J.; Arnér, E.S.J. Reactive oxygen species, antioxidants, and the mammalian thioredoxin system. Free Radic. Biol. Med. 2001, 31, 1287–1312. [Google Scholar] [CrossRef]
- Dumont, S.; Cheng, W.; Serebrov, V.; Beran, R.K.; Tinoco, I.; Pyle, A.M.; Bustamante, C. RNA translocation and unwinding mechanism of HCV NS3 helicase and its coordination by ATP. Nature. 2006, 439, 105–108. [Google Scholar] [CrossRef]
- Appleby, T.C.; Anderson, R.; Fedorova, O.; Pyle, A.M.; Wang, R.; Liu, X.; Brendza, K.M.; Somoza, J.R. Visualizing ATP-dependent RNA translocation by the NS3 helicase from HCV. J. Mol. Biol. 2011. [Google Scholar] [CrossRef]
- Cheng, W.; Arunajadai, S.G.; Moffitt, J.R.; Tinoco, I.; Bustamante, C. Single-base pair unwinding and asynchronous RNA release by the hepatitis C virus NS3 helicase. Science. 2011, 405, 1139–1153. [Google Scholar] [CrossRef]
- Pérez-Villa, A.; Darvas, M.; Bussi, G. ATP dependent NS3 helicase interaction with RNA: Insights from molecular simulations. Nucleic Acids Res. 2015, 43, 8725–8734. [Google Scholar] [CrossRef]
- Dröge, W. Free Radicals in the Physiological Control of Cell Function. Physiol. Rev. 2015, 82, 47–95. [Google Scholar] [CrossRef]

| Gene | Sense Primer Sequence | Antisense Primer Sequence |
|---|---|---|
| pGBKT7- NS3 | ATGGCCATGGAGGCCGAATTC GGGAGGAGTCATCTGGGAT | TGCGGCCGCTGCAGGTCGACG TCTCTTTCCACTCGCAAA |
| pGBKT7- S7 | ATGGCCATGGAGGCCGAATTC GAAAGGAAGAGAGCCGAAG | TGCGGCCGCTGCAGGTCGAC CTTCTTCTTCCTTCTTCTC |
| pGBKT7-DEXDc | ATGGCCATGGAGGCCGAATTC GAAAACATGCTGCGAAAAA | TGCGGCCGCTGCAGGTCGAC CCGAGTTGGAGTCCGGAAA |
| pGBKT7-HELICc | ATGGCCATGGAGGCCGAATTC ATAACAGACTTTCAAGGAA | TGCGGCCGCTGCAGGTCGAC ATCCCTTCCAACCCGTCCA |
| pGADT7-PRDX1 | CCAGTGAATTCCACCCGGGT ATGTCTTCAGGAAAGGCTT | AGCTCGAGCTCGATGGATCCC GTTTCCACTCGGACTGAA |
| pEGFP- PRDX1 | TCAAGCTTCGAATTCTGAC TCGTTGCAACAAATTGATGA | ATCTAGATCCGGTGGATCC TGGGCACTTCTGCTTGGAGA |
| pCAGGS- PRDX1 | TTCGAGCTCATCCATGGTACC ATGTCTTCAGGAAAGGCTT | ATTAAGATCTGCTAGCTCGAG GTTTCCACTCGGACTGAA |
| pCAGGS- HELICc | TTCGAGCTCATCCATGGTACC ATAACAGACTTTCAAGGA | ATTAAGATCTGCTAGCTCGAG ATCCCTTCCAACCCGTCC |
| pGEX-6P-1-HELICc | TCCAGGGGCCCCTGGGATCC ATAACAGACTTTCAAGGAA | GCCGCTCGAGTCGACCCGGGAA ATCCCTTCCAACCCGTC |
| Gene Annotation | Fragment Size (bp) | Repetition | Protein Function |
|---|---|---|---|
| Microsomal glutathione S-transferase 1 (MGST1) | 465 | 3 | Conjugation of reduced glutathione to a wide number of exogenous and endogenous hydrophobic electrophiles. |
| DNA repair endonuclease (ERCC4) | 2742 | 1 | Catalytic component of a structure-specific DNA repair endonuclease responsible for the 5-prime incision during DNA repair. |
| Wnt inhibitory factor 1 (WIF-1) | 1140 | 1 | Binds to WNT proteins and inhibits their activities. |
| WD repeat-containing protein 75 (WDR75) | 2493 | 1 | Ribosome biogenesis factor. Involved in nucleolar processing of pre-18S ribosomal RNA. |
| Peroxiredoxin-1 (PRDX1) | 582 | 4 | Plays a role in cell protection against Oxidative Stress by detoxifying peroxides and as a sensor of hydrogen peroxide-mediated signaling events. |
| Required for rRNA maturation (RPS7) | 597 | 2 | Required for rRNA maturation |
| Golgi resident protein GCP60 (ACBD3) | 486 | 3 | Involved in the maintenance of Golgi structure by interacting with giantin, affecting protein transport between the endoplasmic reticulum and Golgi |
| NADH-ubiquinone oxidoreductase chain 5 (ND5) | 1824 | 3 | Core subunit of the mitochondrial membrane respiratory chain NADH dehydrogenase that is believed to belong to the minimal assembly required for catalysis. |
| l-lactate dehydrogenase A chain (LDHA) | 999 | 1 | Catalytic activity |
© 2019 by the authors. Licensee MDPI, Basel, Switzerland. This article is an open access article distributed under the terms and conditions of the Creative Commons Attribution (CC BY) license (http://creativecommons.org/licenses/by/4.0/).
Share and Cite
Wang, Y.; Zhang, S.; Tang, Y.; Diao, Y. Screening of Duck Tembusu Virus NS3 Interacting Host Proteins and Identification of Its Specific Interplay Domains. Viruses 2019, 11, 740. https://doi.org/10.3390/v11080740
Wang Y, Zhang S, Tang Y, Diao Y. Screening of Duck Tembusu Virus NS3 Interacting Host Proteins and Identification of Its Specific Interplay Domains. Viruses. 2019; 11(8):740. https://doi.org/10.3390/v11080740
Chicago/Turabian StyleWang, Yawen, Shuai Zhang, Yi Tang, and Youxiang Diao. 2019. "Screening of Duck Tembusu Virus NS3 Interacting Host Proteins and Identification of Its Specific Interplay Domains" Viruses 11, no. 8: 740. https://doi.org/10.3390/v11080740
APA StyleWang, Y., Zhang, S., Tang, Y., & Diao, Y. (2019). Screening of Duck Tembusu Virus NS3 Interacting Host Proteins and Identification of Its Specific Interplay Domains. Viruses, 11(8), 740. https://doi.org/10.3390/v11080740





